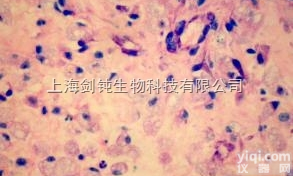
JRD021  姬姆萨<em>染色</em>形态学<em>技术服务</em>

HE染色服务免疫组化实验技术服务
- 产地:上海
- 供应商:上海徕创生物科技有限公司
- 供应商报价: 电议
- 标签:HE染色服务免疫组化实验技术服务,HE染色服务免疫组化实验技术服务价格,HE染色服务免疫组化实验技术服务厂家
HE染色服务免疫组化实验技术服务 免疫组织化学技术又称免疫细胞化学技术,是利用特异性抗原抗体结合性质定量检测化学物质的技术。应用免疫学基本原理--抗原抗体反应,即抗原与抗体特异性结合的原理,通过化学反应使标记抗体的显色剂(荧光素、酶、金属离子、同位素)显色来确定组织细胞内抗原(多肽和蛋白质),对其进行定位、定性及定量的研究。
HE染色服务免疫组化实验技术服务
HE染色
苏木精 — 伊红染色法 ( hematoxylin-eosin staining ) ,简称HE染色法,石蜡切片技术里常用的染色法之一。苏木精染液为碱性,主要使细胞核内的染色质与胞质内的核酸着紫蓝色;伊红为酸性染料,主要使细胞质和细胞外基质中的成分着红色。HE染色法是组织学、胚胎学、病理学教学与科研中基本、使用广泛的技术方法。
徕创生物可提供免疫组化等相关实验如下:
普通包埋
LC-IHC-1001 | 组织石蜡包埋 | 标本 | ¥12 | ||||
LC-IHC-1002 | 细胞石蜡包埋 | 标本 | ¥25 | ||||
LC-IHC-1003 | 琼脂包埋 | 标本 | ¥25 | ||||
LC-IHC-1004 | 特殊包埋 | 标本 | 询价 |
石蜡切片
LC-IHC-1005 | 石蜡切片 | 张 | ¥10 | ||||
LC-IHC-1006 | 组织芯片切片 | 张 | ¥20 |
冰冻切片
LC-IHC-1007 | 冰冻切片 | 张 | ¥10 |
免疫组化
LC-IHC-1008 | 免疫组化/IHC | 张 | ¥30 | ||||
LC-IHC-1009 | 免疫组化(芯片) | 张 | ¥120 |
各种染色
LC-IHC-1010 | HE染色 | 张 | ¥15 | ||||
LC-IHC-1011 | 番红-固绿染色(植物) | 张 | ¥20 | ||||
LC-IHC-1012 | 番红-固绿染色(软骨) | 张 | ¥20 | ||||
LC-IHC-1013 | masson染色 | 张 | ¥20 | ||||
LC-IHC-1014 | 天狼猩红染色 | 张 | ¥20 | ||||
LC-IHC-1015 | PAS糖原染色 | 张 | ¥20 | ||||
LC-IHC-1016 | 阿利新蓝(AB)染色 | 张 | ¥20 | ||||
LC-IHC-1017 | AB-PAS染色 | 张 | ¥20 | ||||
LC-IHC-1018 | 油红O(切片)染色 | 张 | ¥20 | ||||
LC-IHC-1019 | 瑞士吉姆萨染色 | 张 | ¥20 | ||||
LC-IHC-1020 | 甲苯胺蓝染色 | 张 | ¥20 | ||||
LC-IHC-1021 | 尼氏染色 | 张 | ¥20 | ||||
LC-IHC-1022 | 苯胺蓝染色 | 张 | ¥20 | ||||
LC-IHC-1023 | LFB髓鞘染色 | 张 | ¥30 | ||||
LC-IHC-1024 | 普鲁士蓝染色 | 张 | ¥30 | ||||
LC-IHC-1025 | EVG染色 | 张 | ¥30 | ||||
LC-IHC-1026 | 品红VG染色 | 张 | ¥30 | ||||
LC-IHC-1027 | Von kossa染色 | 张 | ¥30 | ||||
LC-IHC-1028 | 茜素红染色 | 张 | ¥30 | ||||
LC-IHC-1029 | 抗酸染色 | 张 | ¥30 | ||||
LC-IHC-1030 | 富尔根染色 | 张 | ¥30 | ||||
LC-IHC-1031 | 间苯二酚碱性品红染色 | 张 | ¥30 | ||||
LC-IHC-1032 | 刚果红染色 | 张 | ¥30 | ||||
LC-IHC-1033 | 快速革兰氏染色 | 张 | ¥30 | ||||
LC-IHC-1034 | 亚甲基蓝染色 | 张 | ¥30 | ||||
LC-IHC-1035 | 黑色素染色 | 张 | ¥30 | ||||
LC-IHC-1036 | 碘-碘化钾染色 | 张 | ¥30 | ||||
LC-IHC-1037 | Goldner三色法染色 | 张 | ¥40 | ||||
LC-IHC-1038 | PAS-萘酚磺S染色 | 张 | ¥40 | ||||
LC-IHC-1039 | 改良苯酚品红染色 | 张 | ¥40 | ||||
LC-IHC-1040 | 网状纤维染色 | 张 | ¥40 | ||||
LC-IHC-1041 | Trap染色 | 张 | ¥40 | ||||
LC-IHC-1042 | β-半乳糖苷酶染色 | 张 | ¥40 | ||||
LC-IHC-1043 | 油红O(大体)染色 | 样本 | ¥40 | ||||
LC-IHC-1042 | PASM 六胺银染色 | 张 | ¥40 | ||||
LC-IHC-1043 | TTC染色 | 样本 | ¥40 |
拍照
LC-IHC-1044 | 拍照(白光) | 样本 | ¥10 |
扫描分析
LC-IHC-1045 | 切片扫描+分析(组化) | 张 | ¥60 | ||||
LC-IHC-1046 | 普通切片扫描(白光) | 标本 | ¥60 |